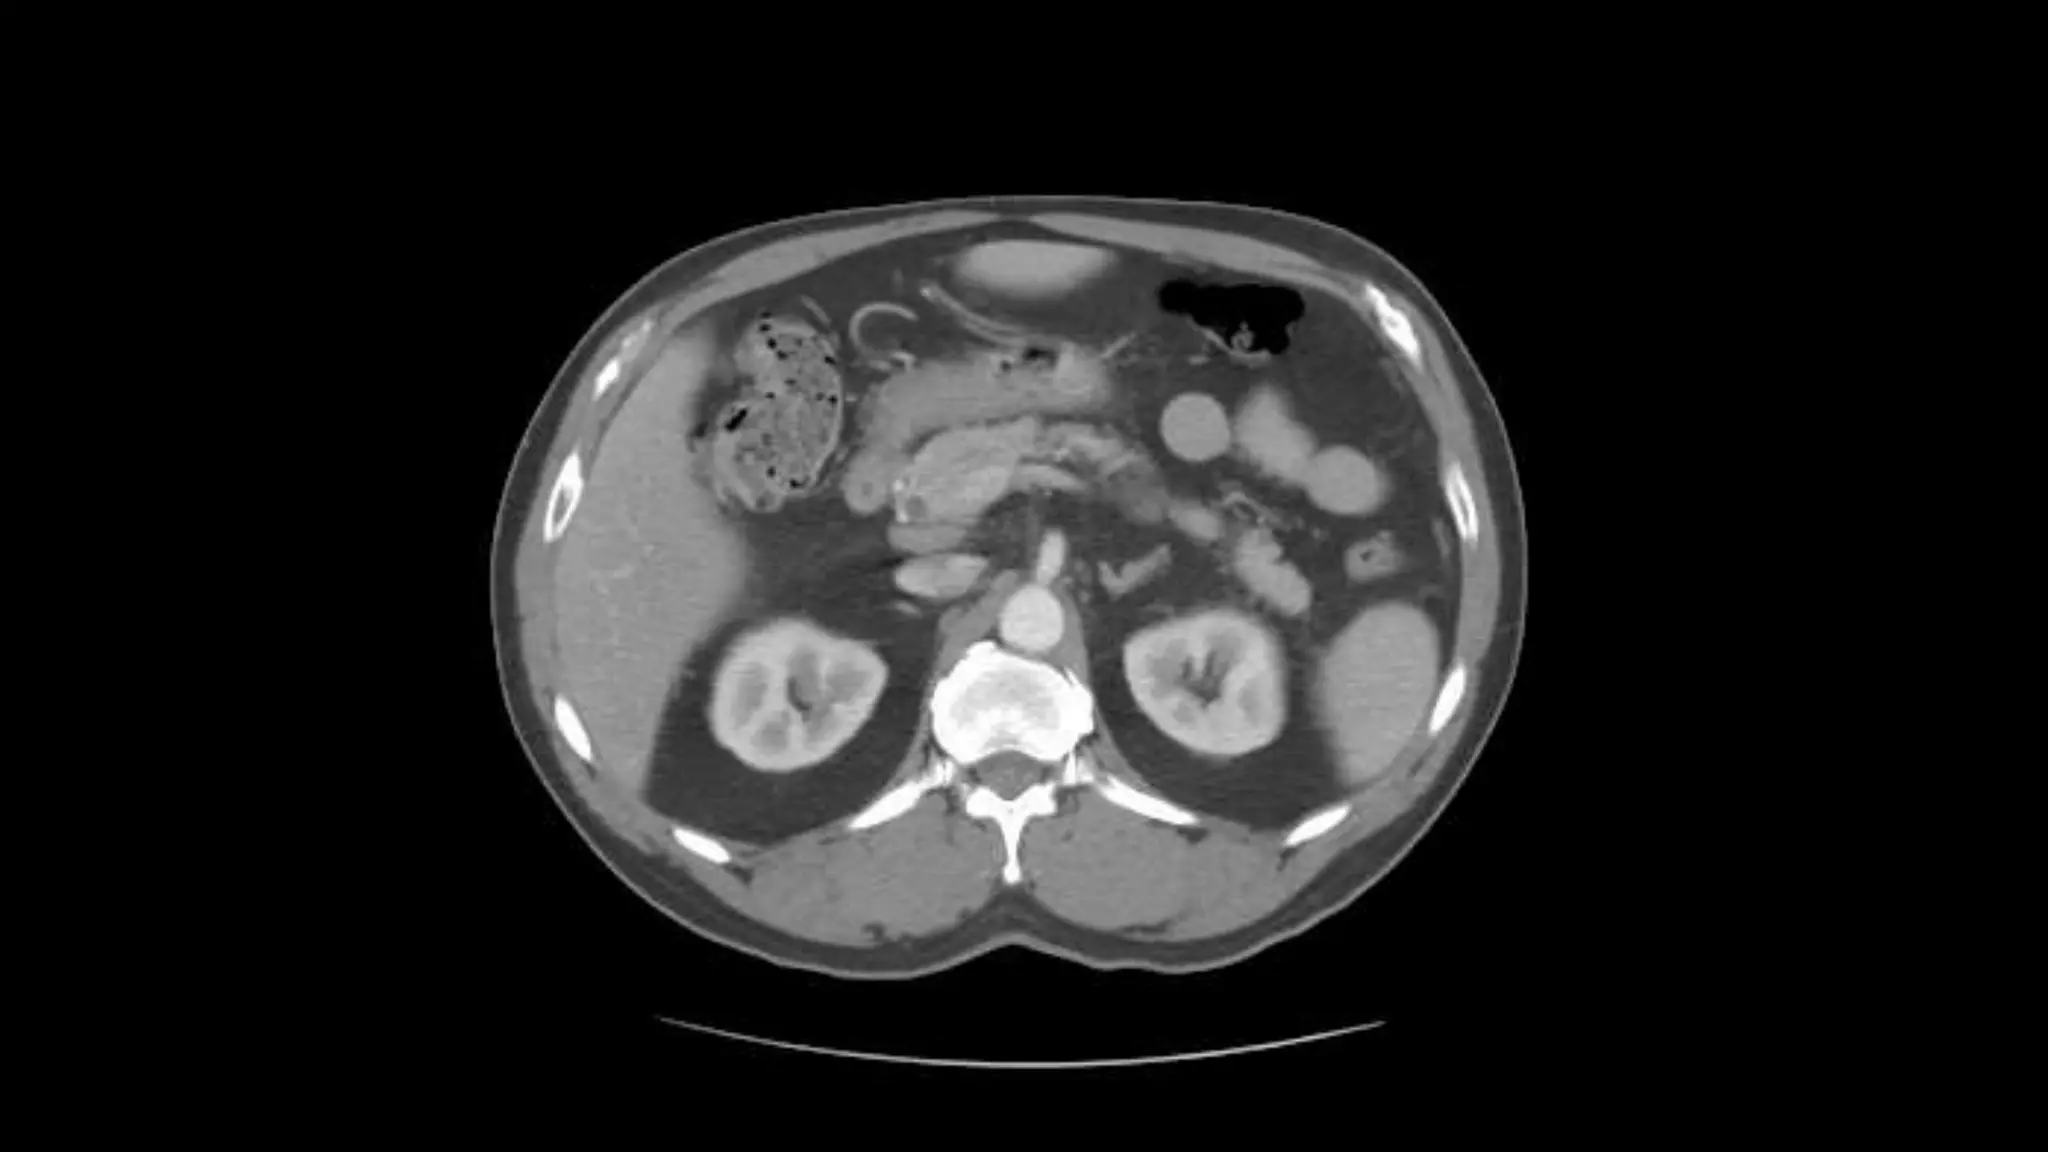
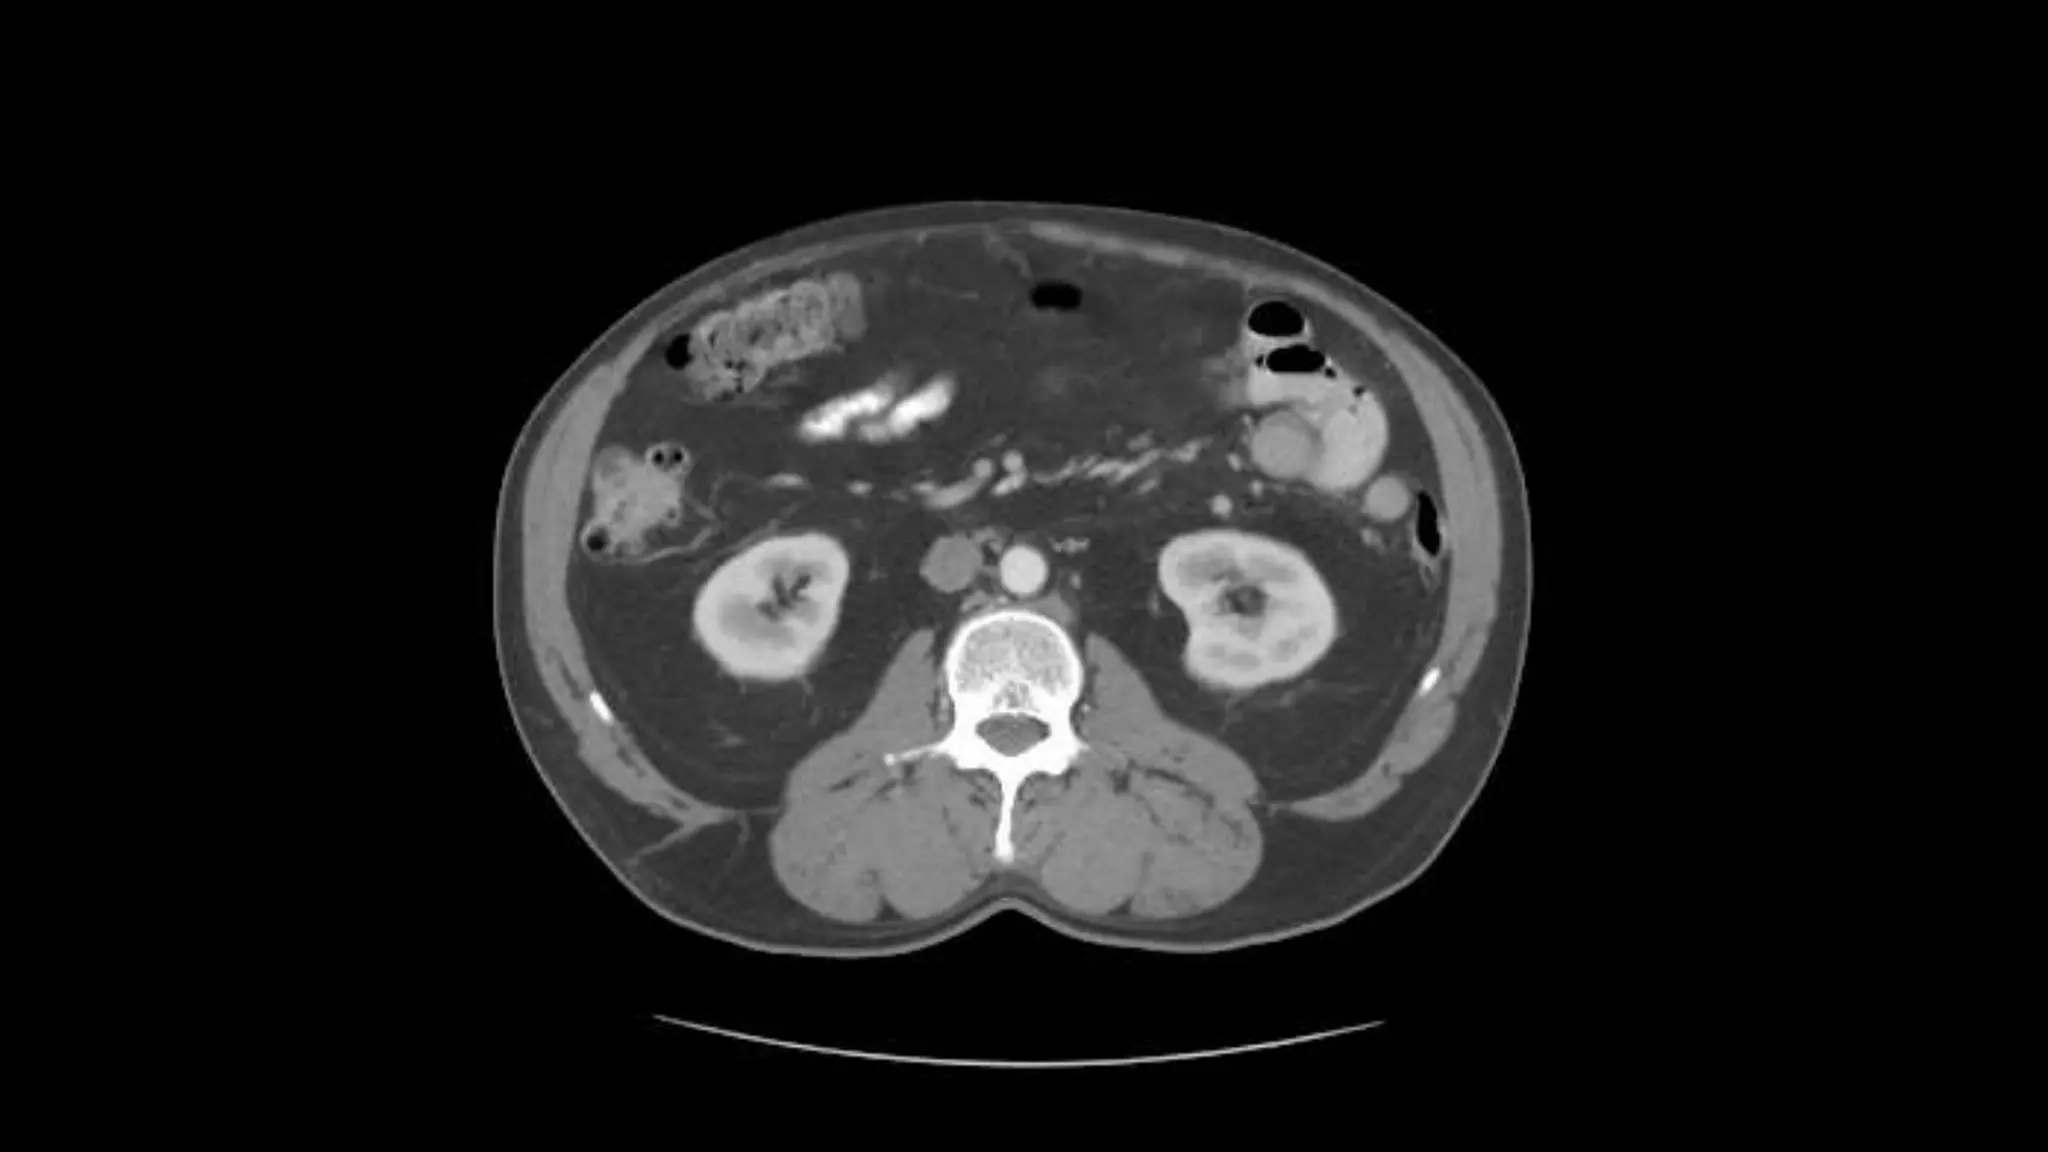
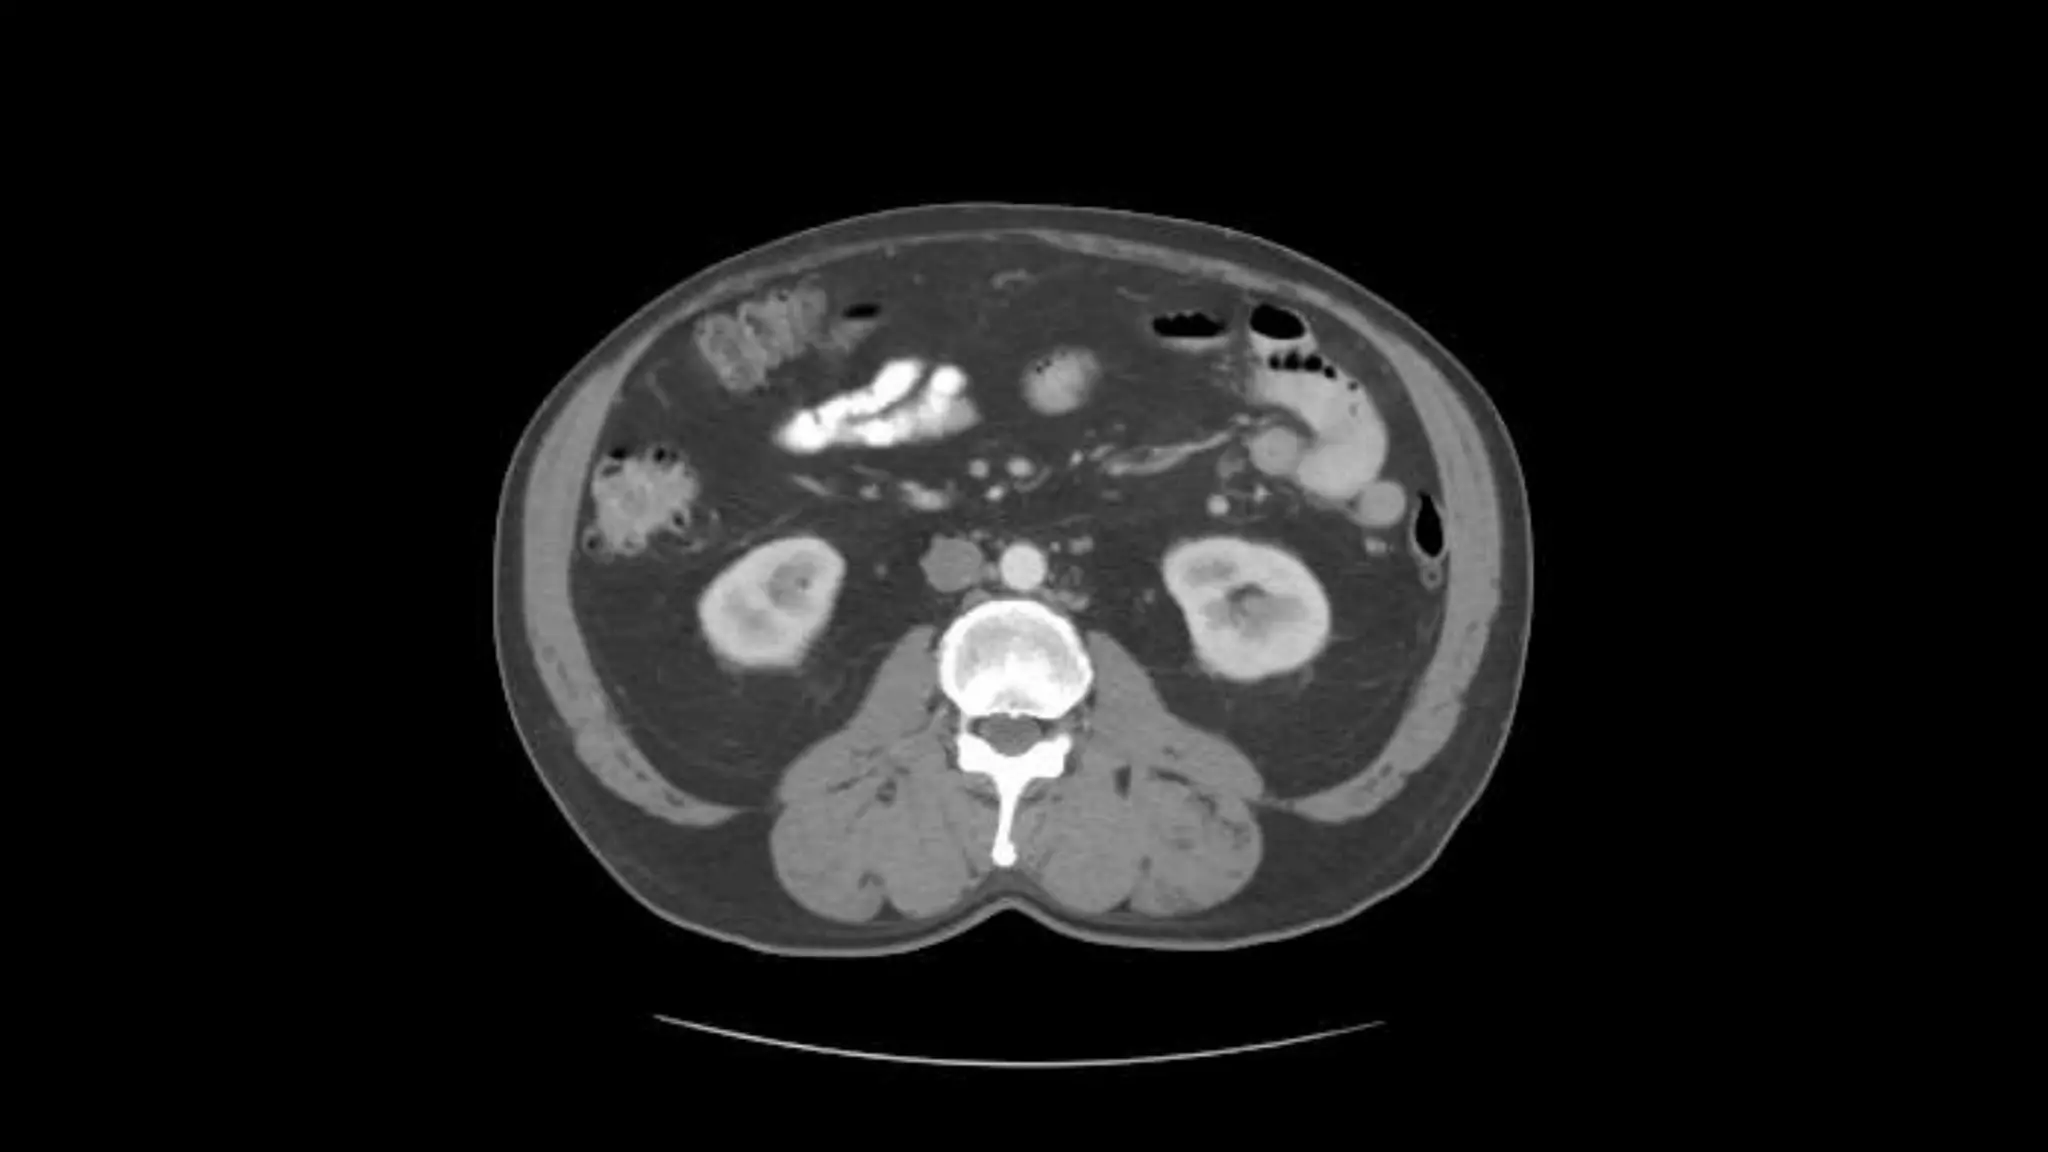
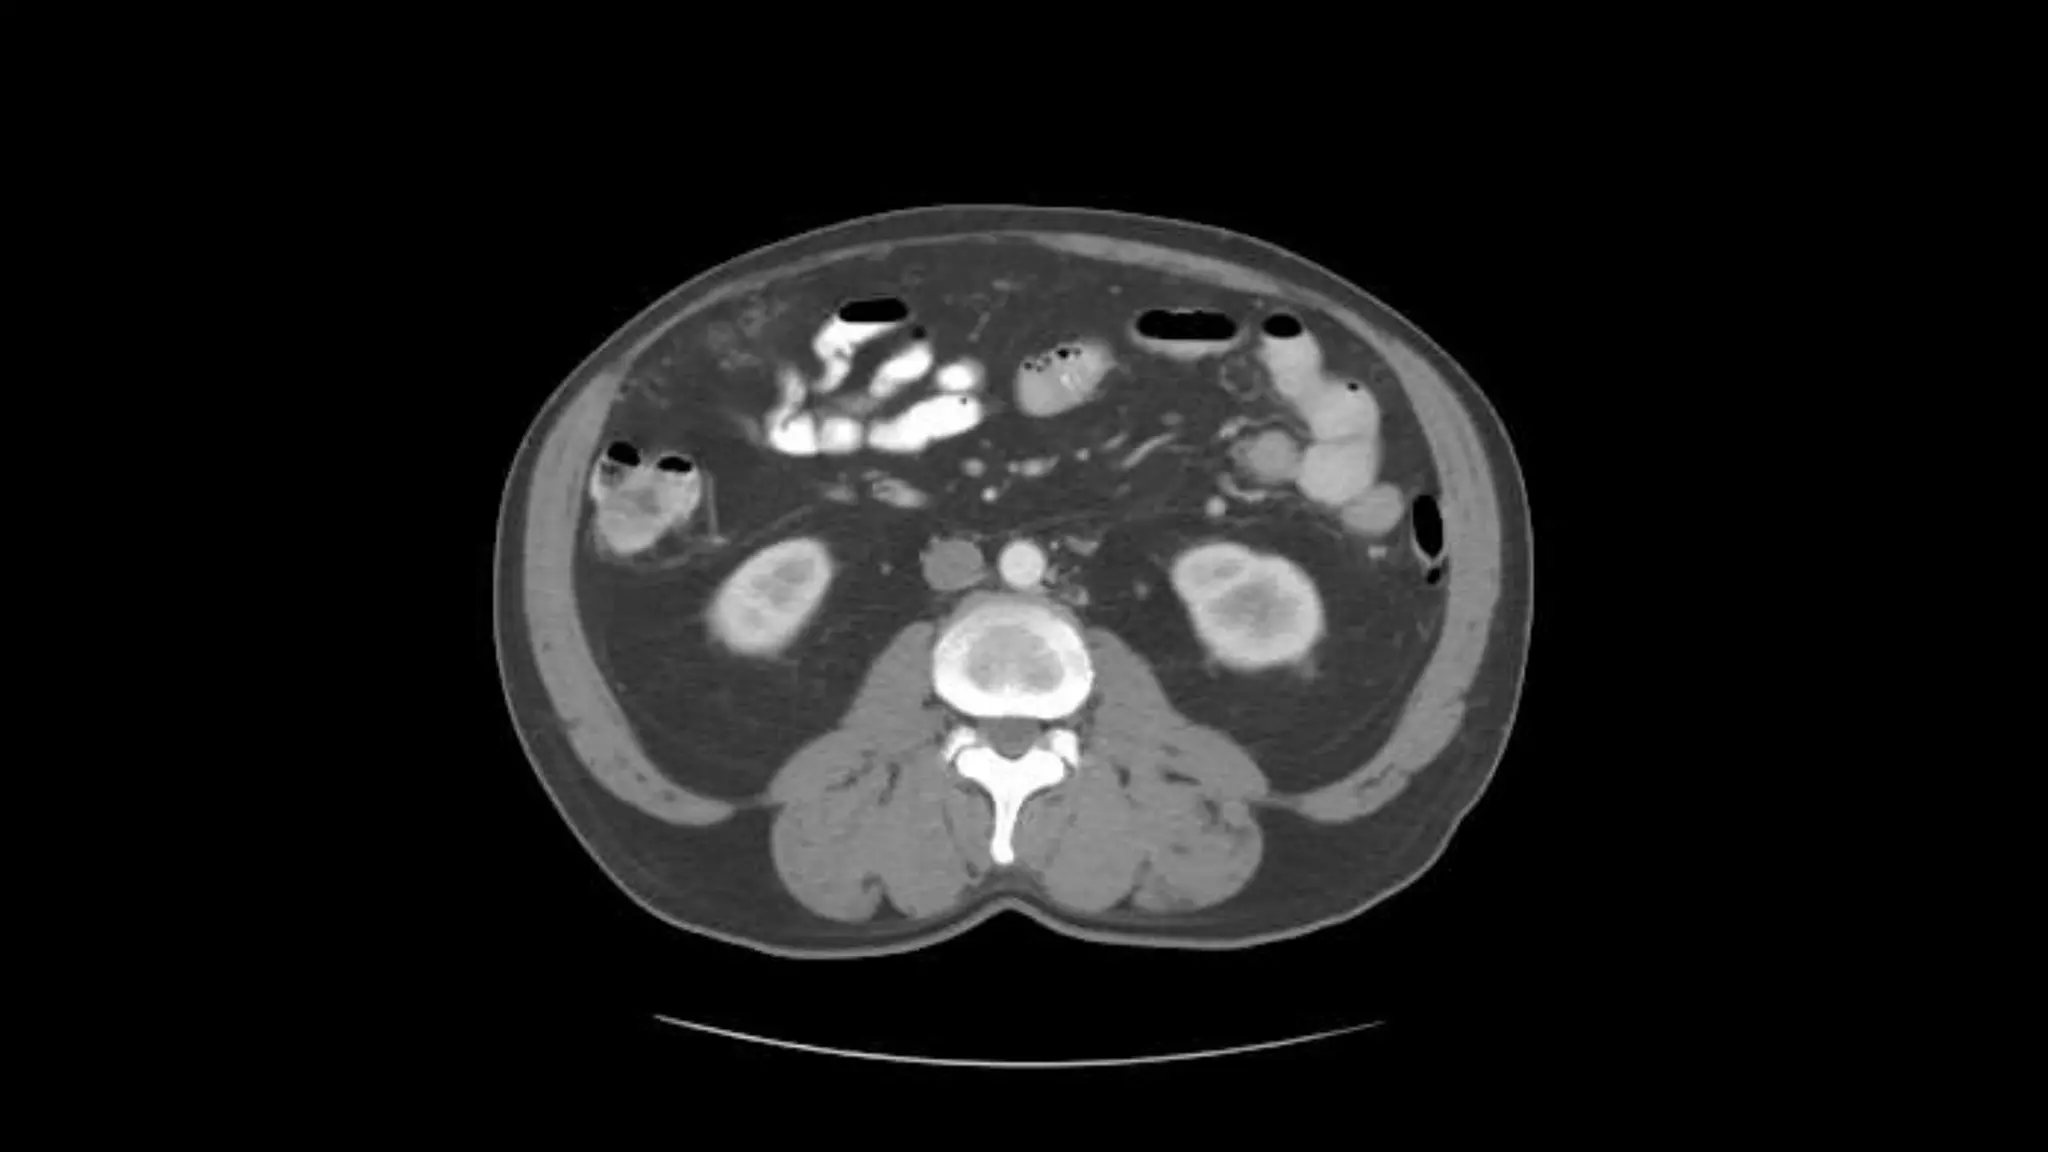
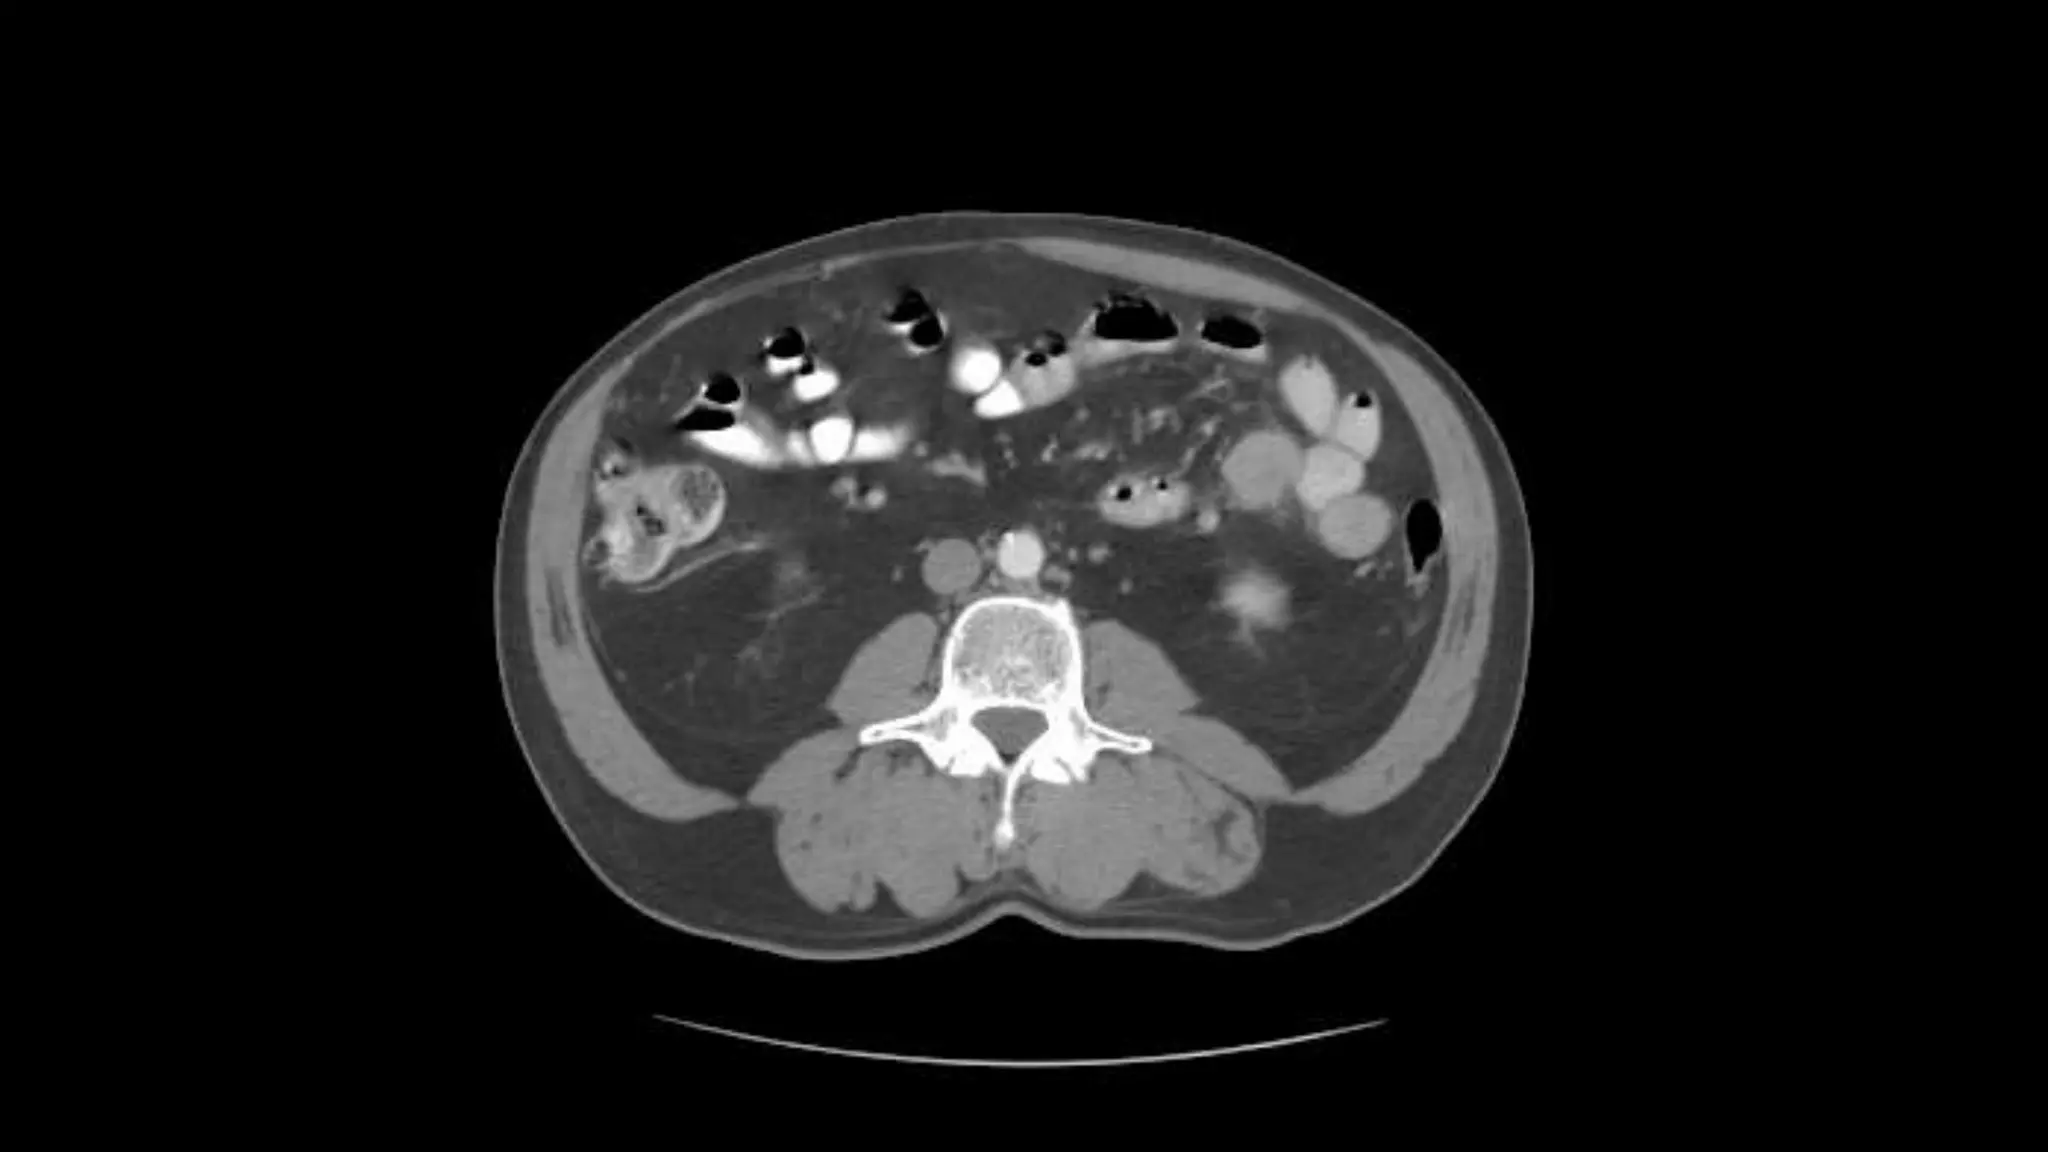
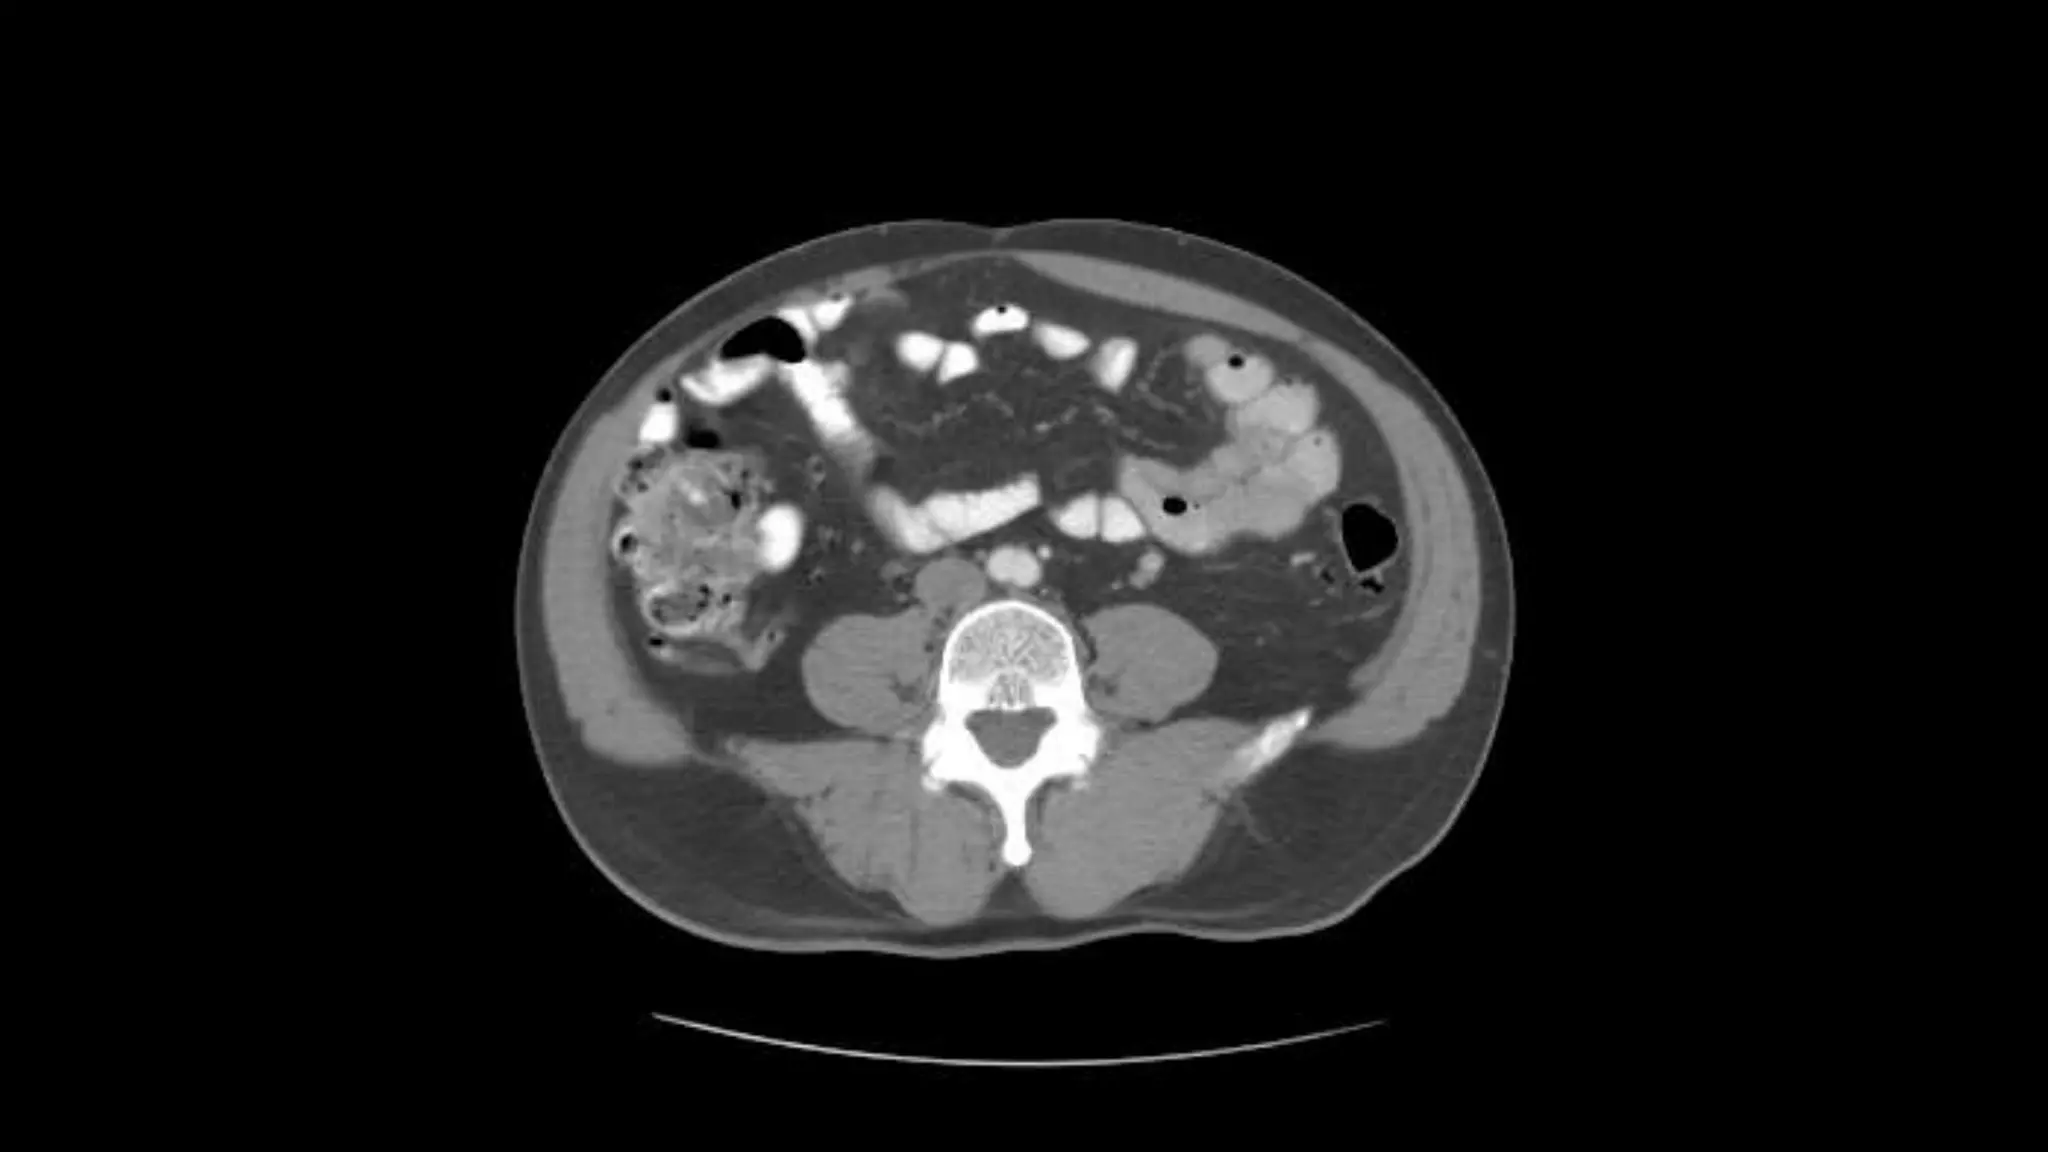

An abdominal CT scan uses x-rays to create detailed cross-sectional images of the abdomen. During the test, the patient lies still on a table that slides into a scanner, which rotates an x-ray beam around the body. Images are created as "slices" and can be combined to form 3D models. An abdominal CT scan is used to detect various abdominal abnormalities such as masses, tumors, infections, kidney stones, and issues affecting the liver, gallbladder, or pancreas. Abnormal results could indicate cancers, organ problems, appendicitis, aneurysms, or other issues requiring follow-up.